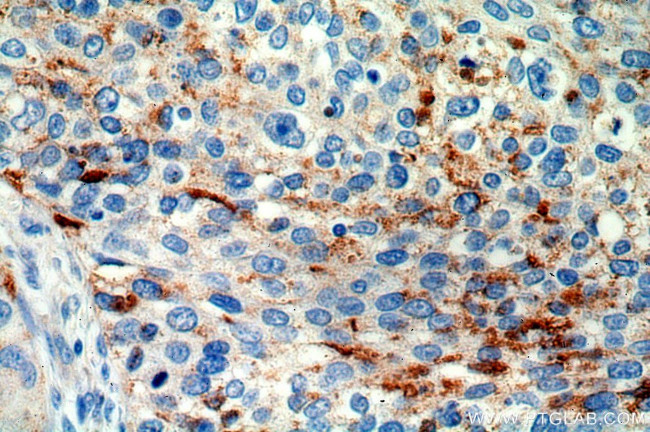
MRPL3 Antibody in Immunohistochemistry (Paraffin) (IHC (P))

Search
Proteintech
MRPL3 Polyclonal Antibody
{{$productOrderCtrl.translations['antibody.pdp.commerceCard.promotion.promotions']}}
{{$productOrderCtrl.translations['antibody.pdp.commerceCard.promotion.viewpromo']}}
{{$productOrderCtrl.translations['antibody.pdp.commerceCard.promotion.promocode']}}: {{promo.promoCode}} {{promo.promoTitle}} {{promo.promoDescription}}. {{$productOrderCtrl.translations['antibody.pdp.commerceCard.promotion.learnmore']}}
产品信息
16584-1-AP
种属反应
已发表种属
宿主/亚型
分类
类型
抗原
偶联物
形式
浓度
规格
纯化类型
保存液
内含物
保存条件
运输条件
产品详细信息
Immunogen sequence: MPGWRLLTQ VGAQVLGRLG DGLGAALGPG NRTHIWLFVR GLHGKSGTWW DEHLSEENVP FIKQLVSDED KAQLASKLCP LKDEPWPIHP WEPGSFRVGL IALKLGMMPL WTKDGQKHVV TLLQVQDCHV LKYTSKENCN GKMATLSVGG KTVSRFRKAT SILEFYRELG LPPKQTVKIF NITDNAAIKP GTPLYAAHFR PGQYVDVTAK TIGKGFQGVM KRWGFKGQPA THGQTKTHRR PGAVATGDIG RVWPGTKMPG KMGNIYRTEY GLKVWRINTK HNIIYVNGSV PGHKNCLVKV KDSKLPAYKD LGKNLPFPTY FPDGDEEELP EDLYDENVCQ PGAPSITFA (1-348 aa encoded by BC003375 )
靶标信息
Mammalian mitochondrial ribosomal proteins are encoded by nuclear genes and help in protein synthesis within the mitochondrion. Mitochondrial ribosomes (mitoribosomes) consist of a small 28S subunit and a large 39S subunit. They have an estimated 75% protein to rRNA composition compared to prokaryotic ribosomes, where this ratio is reversed. Another difference between mammalian mitoribosomes and prokaryotic ribosomes is that the latter contain a 5S rRNA. Among different species, the proteins comprising the mitoribosome differ greatly in sequence, and sometimes in biochemical properties, which prevents easy recognition by sequence homology. This gene encodes a 39S subunit protein that belongs to the L3P ribosomal protein family. A pseudogene corresponding to this gene is found on chromosome 13q.
仅用于科研。不用于诊断过程。未经明确授权不得转售。
生物信息学
蛋白别名: 39S ribosomal protein L3, mitochondrial; L3mt; Large ribosomal subunit protein uL3m; mitochondrial 60S ribosomal protein L3; mitochondrial large ribosomal subunit protein uL3m; MRP-L3; MRPL3; unnamed protein product
基因别名: 2010320L16Rik; 5930422H18Rik; AA407889; COXPD9; MRL3; MRPL3; RPML3; uL3m
UniProt ID: (Human) P09001, (Mouse) Q99N95
Entrez Gene ID: (Human) 11222, (Rat) 300974, (Mouse) 94062